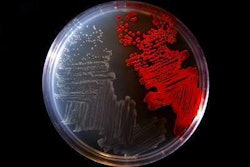
A culture plate shows the colorless bacterium Serratia marcescens strain sicaria (left) and another type of bacteria (right). Photo: University of Wisconsin-Stout

Garza’s Green Grass employs 10-12 people, including a few part-time workers, and has operations in both Oklahoma City and Lawton.For the Garza brothers of Oklahoma, who grew up in their parents’ restaurant business, work remains a family affair.
Dennis Garza oversees Garza’s Green Grass landscaping work in Oklahoma City, while brothers Danny and David handle the company’s Lawton, Oklahoma, operations. Another brother runs an affiliated company, Estrella Pools & Designs.
Garza’s Green Grass has been around for more than 20 years now, going back to the days when Dennis Garza began driving around Oklahoma City with a mower in the trunk of his car to handle lawn-care jobs part time. Dennis still has another job, as does his brother Danny, who teaches algebra and coaches the girls’ basketball team at a school in Lawton. Brother David, meanwhile, who also worked in education, is leaving that position to devote full time to the landscaping business.
Danny Garza said he, too, plans to leave education soon and give his full attention to landscaping.
Dennis Garza prepared detailed landscape design plans for his son’s elementary school at no charge.Photo: Garza’s Green Grass
The brothers say the success of Garza’s Green Grass has been steady, with 2016 revenue expected to top $400,000. The company employs between 10 and 12 full and part-time employees and has five additional workers who are regularly called in for bigger jobs.
The key to the company’s growth, says Dennis Garza, is treating customers as you would family members. He says the company is known – among both customers and suppliers – for honesty and fair dealing, which Garza attributes to “our deep faith in God.”
Garza’s Green Grass serves commercial and residential clients, providing lawn care, including weed control and fertilization, landscape design/build, sod installation, Christmas lighting, snow removal and related services.
In a recent interview with Dennis and Danny Garza in Oklahoma City, the brothers began the day by visiting Dennis’s son’s elementary school to present an in-depth design – prepared at no cost to the school – for major landscape renovations.
Dennis talked with the school’s principal and PTA volunteers for more than hour, later walking the grounds with them on a sunny but cold December morning. Garza’s plans were a hit. Another presentation would be scheduled for the full PTA.
The brothers say all their customers, including individual homeowners purchasing only the company’s Christmas lighting services, are “treated like we would want to be treated,” in Danny Garza’s words. Still, he and Dennis say the company’s growth in recent years is owing to its large jobs, from the landscaping for a new location of a major hotel chain to Oklahoma City’s newest event center, The Montellano.
The event center job is one the brothers say they aren’t likely to forget. The extensive design work by Garza’s Green Grass called for numerous plantings surrounding the 10,000-square-foot venue. Dennis Garza said his longtime relationship with a major nursery in the city ensured that he would receive high-quality plants, on time. And that’s exactly what happened.
The Garza brothers love to show off The Montellano Event Center’s landscaping, but a water scheduling snafu complicated an otherwise ideal commercial project.Photo: Garza’s Green Grass
The problem, however, was water. Danny Garza shakes his head as he recalls the news the brothers received as all those trees, shrubs and flowers were being installed: Bringing water to the site had been delayed. It could be several days.
Dennis Garza says the brothers and some of their workers made countless trips to the site to bring in water for the plants. New plantings need extra care, he said, and there was no way the Garza brothers were going to allow the large installation project to be undone by a scheduling snag. Despite the extraordinary challenges involved, both Dennis and Danny take obvious pride in The Montellano job.
Homeowners associations and maintenance contracts with shopping centers are important sources of recurring income, but Dennis Garza says the company will continue to target large construction projects calling for design and installation. They’re not only the best source of real growth, he says, they often contribute to recurring income because the owner will contract with Garza’s to maintain the landscape it designed and installed.
“That’s what comes from doing the job well,” said Dennis Garza. “And building relationships.”